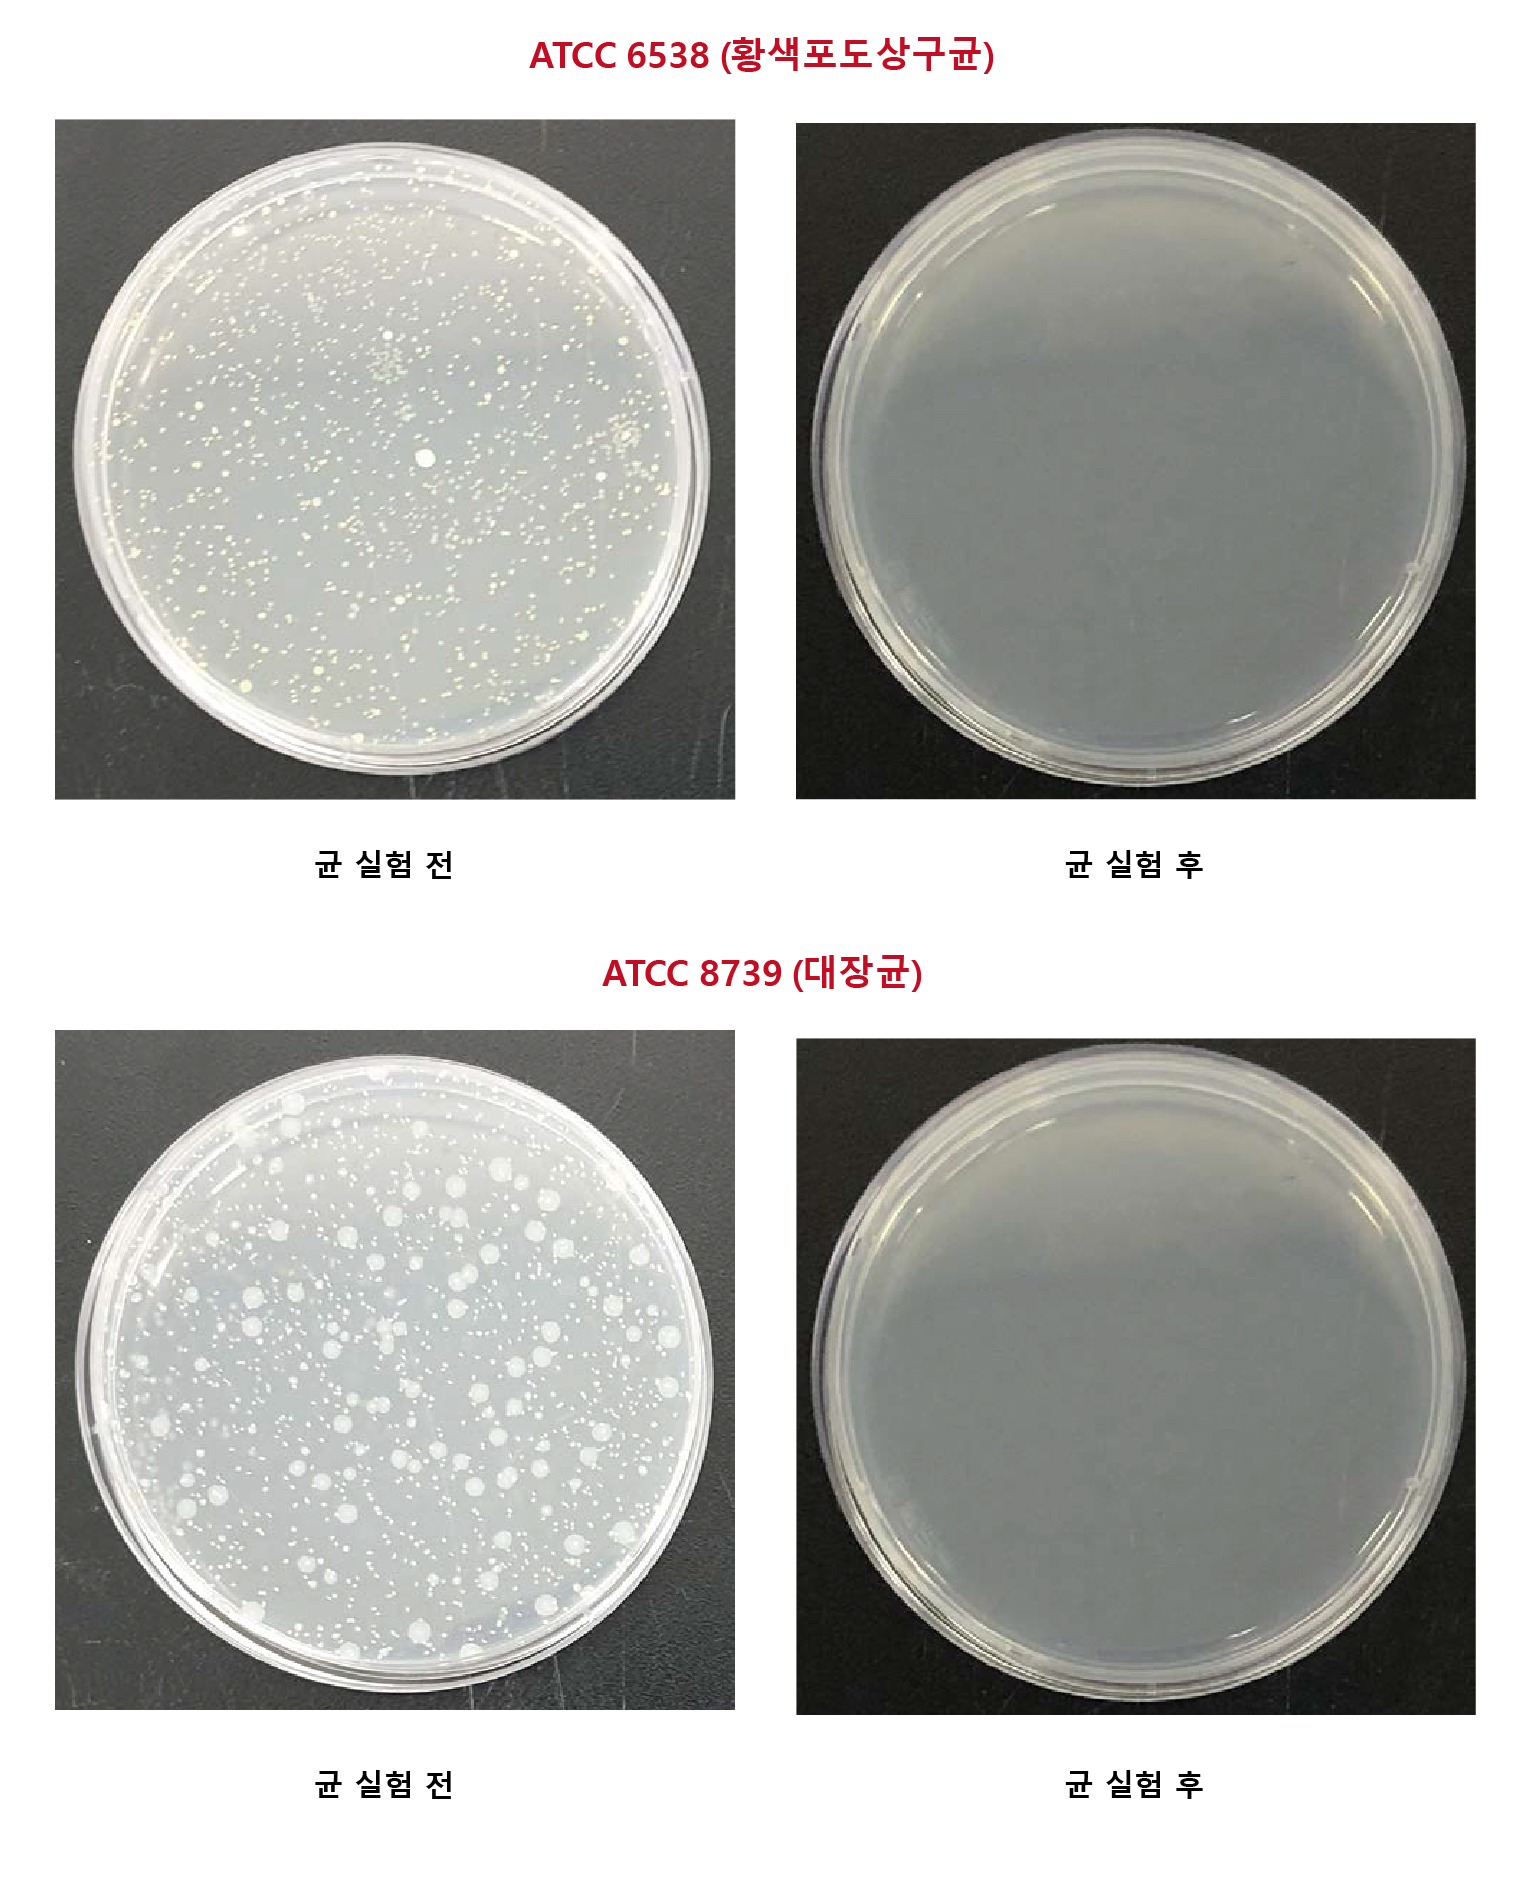

고리형 휴대용 손소독제
헤아림의 히트상품(?)을 소개해드리려고 합니다 :)
바로 고리형 휴대용 손소독제 입니다.
상반기 코로나로 인해 모두들 힘들게 보내고 있는데요
그시기에 많이 사랑받은 천연손소독제 입니다.
오프라인 매장에서 주로 판매가 되었고
매장 테이블에 비치되어 테스를 해보시고는
모두들 겟하신 제품이랍니다 ^^
이제 코로나가 장기화가 되면서
헤아림도 깊은 고민을 했답니다.
누구나 쉽게 생활방역을 할 수 있는 것은 어떤것이 좋을까?
가장 취약한 것은 아무래도 어린 아이들이겠죠~
그래서 항상 지니고 다닐수 있는 고리형으로 제품을 출시했답니다.
엄마들 보냉가방 많이들 들고 다니시죠? 거기에도 좋구요
유모차에도 달아두면 아이들이 알아서 사용할 수 있어요
내가 움직이는 어느곳에든 함께 할 수 있습니다.
보습성분이 많이 들어가서 자주사용해도 전혀 트지않아요~
화장품 보다 더 많은 양이 들어갔답니다.
그래서 가격은 살짝 있지만 위생과 피부를 위해 사용하는 제품이니
성분을 많이 고려했답니다 :)
용량 : 50ml
가격 : 6,500원
배송료 : 3,000원( 5만원 이상 무료배송)
당연히 스팀/스달/한화 모두 가능하고, 업비트 실시간 가격으로 측정합니다.
대량으로 판매하실 생각이 있으신 분들께는 도매가로 납품할 생각이 있으니
혹 생각 있으신 분들은 연락주셔도 좋습니다
※단 온라인 판매는 납품하지 않아요:D

오랜만에 뵙습니다.
glory7 님~ 반겨주셔서 감사합니다~ 잊지 않으셨군요!! ㅎ
안녕하세요.
안녕하세요~ 뭔가 챠크라 적인 느낌이 드는데요???ㅎ
달고 다니면 편하겠군요
네 정말 편해요! 오프라인에서는 선물용으로도 많이 나갔답니다 ㅎ
진짜 아이디어 상품이네요. ^^
관심 갖어 주셔서 감사합니다~ 반갑습니다 :)
오랫만이에요.
날로 번창하시는군요^^
우리 한 번 더 뭉쳐야 할 텐데요. ^^
코로나 때문에 타임을 봐야할듯해요 ㅎㅎ
네 호돌님~ 오랜만입니다!! 그사이 레벨업이 엄청 되셨네요 ㅎㅎㅎㅎ 축하드려용!!